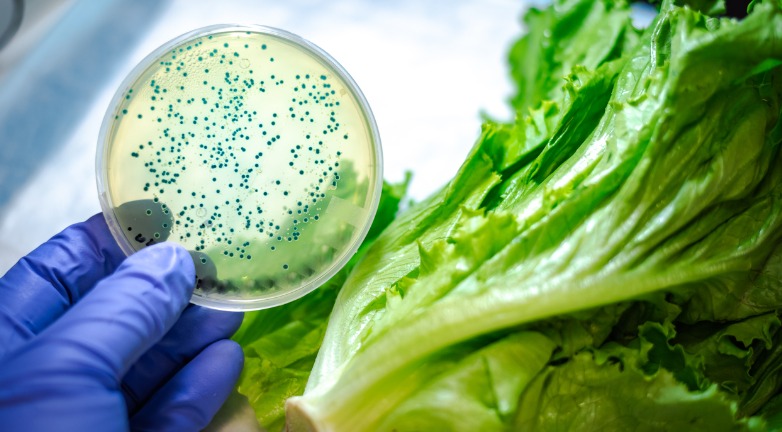

After blockchain technology has proved its use in a variety of fields and industries, the digital ledger has officially secured its place in the financial markets. Two exchange-traded funds (ETFs) focused on blockchain technology launched last week to help investors take advantage of the digital platform’s popularity and growth.
CNN’s Paul R. La Monica reports that the new Reality Shares Nasdaq NexGen Economy and Amplify Transformational Data Sharing ETFs each own shares in the increasing number of companies that utilize blockchain technology. An ETF acts like a stock and tracks an index or commodity, with its price rising and falling as transactions happen.
As a refresher, a blockchain is a peer-to-peer ledger hosted on a decentralized network. This means that there is not one central authority that controls the system. Instead, users have their own copies of the ledger, and they run algorithms to verify new transactions. Blockchain technology was originally used to securely record transactions made with bitcoin and other cryptocurrencies, but its use has expanded to track other types of transactions and even product information. This means that, although bitcoin needs blockchain, blockchain technology does not need bitcoin. Therefore, this month’s cryptocurrency crash will not have a huge impact on the stock market value of blockchain technology.
Both the Reality Shares and Amplify ETFs own shares of IBM, which recently partnered with Maersk and a variety of food manufacturers and retailers to use blockchain technology to manage their supply chains. The ETFs also invest in Intel, which creates the software and chips to encrypt cryptocurrency transactions, and online retailer Overstock, which has been experimenting with blockchain technology through its Medici Ventures unit and tZero digital coin exchange. In addition, the ETFs invest in financial groups that could benefit from blockchain technology. Reality Shares has stakes in Nasdaq and Barclays, and Amplify holds shares of Goldman Sachs and Citigroup.
The ETFs do have their differences. Reality Shares is based on an index of blockchain-related companies that it recently launched with Nasdaq. This index is rebalanced twice a year, and the fund’s holdings are adjusted at the same time. Amplify is actively managed and can make changes to its holdings more frequently.
You might also notice that the words blockchain, bitcoin and cryptocurrency are not included in the names of these ETFs. La Monica reports that this is intentional, as the U.S. Securities and Exchange Commission (SEC) is concerned that some companies’ stock prices are rising simply because they have said they are using blockchain technology or because they have included those words in their company names. For example, Long Island Iced Tea Company changed its name to Long Blockchain Corporation last year and announced that it was seeking to partner with and invest in companies that develop blockchain technology. As a result, its shares jumped nearly 300 percent, Bloomberg reports.
"Investors have been buying blindly, and there has been some abuse," said Amplify CEO Christian Magoon. "The SEC has to protect investors."
Reality Shares CEO Eric Ervin told CNN that the ETF approaches the market with a similar caution. Its index is based on a rigorous review of companies’ involvements with blockchain. “We’re not going to accept Kodak just because it’s suddenly decided to do something with blockchain,” Ervin said. Earlier this month, Kodak announced plans to launch a photo-centric cryptocurrency called KODAKCoin. This announcement boosted Kodak’s stock price by 125 percent. Amplify has chosen to invest in the company’s potential, but Magoon said the ETF’s leadership is wary of companies that are trying to ride bitcoin and blockchain’s popularity wave. “We don’t want scam stocks,” he said.
In addition, the SEC is cautious of approving funds that solely invest in cryptocurrency and related products. However, because Reality Shares and Amplify focus on companies that are investing in blockchain technology, they have been approved as ETFs.
Both ETFs have experienced slight growth in their first few weeks on the market. Reality Shares is up approximately 2.5 percent to just less than $25 a share, and Amplify has grown 4.7 percent to just more than $21 a share. Of course, as the technology develops and more uses are discovered, the market interest likely will follow.
Supply chain for the future
For now, blockchain’s best-known benefit for supply chains is the technology can help companies securely manage information about their multiple tiers of suppliers, products, manufacturing processes, transactions and more. In "Blockchain: Harnessing Data, Enabling the Future IoSC," the APICS Research, Innovation & Strategy Committee reports that enterprises will need to be able to ensure the quality and integrity of their data. They also will need to monitor the way data is used in application-driven processes and related infrastructure. The authors note that the best approach to this could be a blockchain.
Having a secure, digital information ledger also enables all members of a supply chain to seamlessly share accurate, standardized data with one other. This can be especially useful to prevent and contain risks. For example, IBM has been working with food manufacturers and retailers to use blockchains to track items in their supply chains. In the event of a foodborne illness, manufacturers and retailers could review the blockchain data to pinpoint the cause of the issue and identify the affected products. Then, retailers could remove those products from shelves to contain the risk.
APICS offers a variety of resources to help you better manage traditional and emerging supply chain risks. Learn more about what APICS can do for you at apics.org.